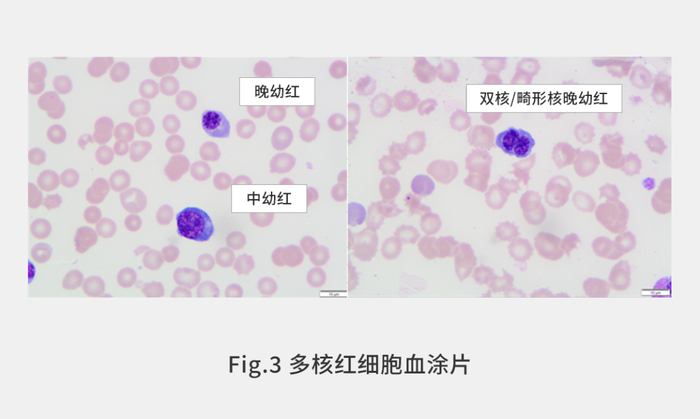

转自:迈克生物
有核红细胞(Nucleated Red Blood Cells, NRBC)是未完全成熟的红细胞,可以分为早幼红细胞、中幼红细胞和晚幼红细胞,通常存在于骨髓等造血组织或器官中。正常情况下,外周血中不出现此类细胞。在出生1周之内的新生儿外周血中可见到少量有核红细胞存在。成人外周血中出现有核红细胞均属病理现象[1~3]。
核酸荧光染色是现在血细胞分析仪主要采用的方法。其检测原理是仪器将样本进行溶血剂处理后,使用特定的核酸染料进行染色,采集样本的侧向荧光信号、前向散射光和侧向散射光信号进行白细胞总数和子类检测。
而有核红细胞被溶血剂处理后,还会残留有核红细胞的核,内部的核酸含量和淋巴细胞的含量基本一致,形态大小基本一致,也会导致有核红细胞被误识别为淋巴细胞,计入到白细胞的总数中(图1所示)[4~6]。

研究发现在酸性试剂条件下,样本中的嗜碱性粒细胞和有核红细胞可以完整保持形态特征,而细胞膜被一定程度的破损便于特定荧光染料进行染色,红细胞等溶血后变成不影响测量的透明碎片。
通过采集样本的侧向荧光信号、前向散射光和侧向散射光信号进行白细胞总数检测。以侧向散射光信号为X轴,以前向散射光信号为Y轴绘制二维散点图时,各个细胞成群分布,有核红细胞的分布位置独立于白细胞,如图2所示。
在这种散点图中,有核红细胞比粒细胞(中性粒细胞、嗜碱性粒细胞和嗜酸性粒细胞)形态小,所以出现在前向散射光强度比粒细胞弱的区域。同时有核红细胞的核膜破坏程度要小于粒细胞,荧光染料较难通过细胞膜与胞内的核酸物质结合,所以出现在荧光强度弱的区域。嗜碱性粒细胞出现在荧光强度比嗜酸性粒细胞和中性粒细胞小的区域,因此也能够将嗜碱性粒细胞和其他粒细胞明确的区分开。
为了消除这种有核红细胞被误识别为白细胞的情况,并能够精准计数样本中的有核红细胞,迈克公司研发的8系列血液细胞分析仪产品均采用了该技术原理对样本中的有核红细胞和嗜碱性粒细胞进行准确测试。


临床实验中有一类样本的血涂片镜检呈现红细胞系统有巨幼样变,双核和核间染色质桥,大细胞增多,中幼红细胞和晚幼红细胞常常具有多个核,可以达到2~12个(图3所示)。同时能够见到核破裂。在不同的分期阶段中,还能看到巨大的幼红细胞,细胞内有嗜碱性红细胞/嗜多色性红细胞。临床上称之为幼红细胞多核症[7,8]。该类样本具有无效红细胞造血和/或外周红细胞破坏增加的表现,骨髓红细胞系统增生旺盛,可见10~15%以上的双核和多核的幼红细胞。
多核红细胞的形态体积要大于正常的有核红细胞,胞内的核酸物质的量增多,其细胞膜在试剂中容易被损坏,会被荧光染料特异的染色,采集到的荧光信号增加,部分落入到嗜碱性粒细胞(BASO)区域,导致BASO的计数假性增加。
在该例中,未进行正确识别的仪器报告样本BASO%为5.2%。样本涂片镜检的结果显示BASO%为0%,即样本中不含有嗜碱性粒细胞。
通过优化仪器的试剂和算法等,改善了多核红细胞的识别。该例样本重新检测结果显示NRBC%的数值为13%,BASO% 的数值降低为0.1%,和镜检结果基本一致,如图4所示。从而避免了多核红细胞存在导致仪器对有核红细胞的误识别。


研究表明在慢性淋巴性白血病和恶性淋巴瘤等疾病中,外周血中会出现肿瘤性成熟淋巴细胞;在急性白血病中,则会出现未成熟的异常的单核细胞。在恶性肿瘤患者外周血中,机体会局部缺氧,促进红细胞生成素(EPO)的合成,调节骨髓对红细胞的释放,部分NRBC释放入血。临床中发现出生一周之内的新生儿外周血片中可见到少量有核红细胞。体内有核红细胞增多,可能是缺氧所致。机体在缺氧时血氧、血红蛋白水平下降,通过刺激机体内的促红细胞生成素释放,可使机体内未成熟的红细胞生成增多,代偿增多的未成熟红细胞释放入血液循环,从而改善机体缺氧状况[9]。
当体内有核红细胞的数量增多到与白细胞相当或者多于白细胞的数量,则可能会干扰白细胞的计数。
在图5所示样本中,WBC的数量为2.52×109/L,样本涂片镜检报告NRBC 120/100 WBC。在未优化的系统中,样本二维散点图5A所示。从图中可以看出,有核红细胞存在的区域和白细胞存在的区域基本重合,导致白细胞假性增加。原因是在这类样本中,由于白细胞的数量较少,试剂除了对白细胞的膜进行了破坏,部分有核红细胞的膜也遭到试剂的破坏,增加了染料对的膜通透性,增强了有核红细胞的荧光信号,导致部分信号和白细胞的区域重合。
在优化试剂反应体系和算法识别后,使得有核红细胞的膜结构增强,较难被试剂破坏,从而增大了和白细胞的信号差异,容易被准确识别到。在优化后的系统中,如图5B所示,该样本中的有核红细胞能够被精准识别,NRBC#为3.57×109/L、NRBC%为89.8%,符合人工镜检结果。


网织红细胞(Reticulocyte)是介于晚幼红细胞和成熟红细胞之间的未完全成熟的红细胞。网织红细胞进一步成熟,RNA消失而为成熟红细胞。在正常情况下骨髓中有核红细胞并不释放至血循环,只有网织红细胞和成熟红细胞才释入血中[10]。
正常人外周血中几乎都是较成熟网织红细胞,在外周血中48小时左右即可转化为成熟红细胞,但在血液病或药物等因素影响时可促使幼稚的有核红及网织红提前释放入血,导致了晚幼红细胞和高荧光有核红细胞的增高。
该类样本一例如图6所示,检测结果显示RET%数值为13.8%,IRF指数(该指数值升高表明样本中存在着大量的晚幼红细胞等较不成熟的网织红细胞)高达59%(图6B所示),同时在有核红检测通道中,提示有核红细胞不存在,和血涂片人工镜检结果有差异(图6A所示)。

导致有核红细胞不能被识别的原因在于样本中存在着大量的晚幼红细胞,该类细胞在形态体积上接近于白细胞,细胞内的核酸物质量也接近白细胞。在网织红细胞检测通道中,它分布在网织红细胞的高荧光区域,部分粒子落入了白细胞分布的区域。在有核红细胞检测通道,由于细胞核膜被破坏的程度高于早幼红细胞和中幼红细胞,被荧光染料染色的程度接近白细胞,荧光信号超出了有核红细胞识别的阈值,被误识别成白细胞。
在经过优化的系统中,对于这类样本通过设定两类机制进行提升准确性。当用户同时进行网织红细胞检测和有核红细胞检测,则在有核红细胞检测通道中引入一个IRF判定阈值(来自网织红细胞检测通道),若样本的IRF超过了设定阈值,给出一个修正参数,用于对有核红细胞的计数进行修正。如用户测量过程中仅进行有核红细胞的检测,则根据该类样本中二维散点图呈现的特征,引入散点图异常判断规则,向使用者给予报警信息,提示样本重测。
该样本在放置24小时后重新测试,NRBC%计数为140%,和血涂片镜检结果一致。仪器检测结果如图7所示。

通过分析血细胞分析仪的检测原理差异,多核红细胞样本、有核红细胞异常增加、未成熟网织红细胞等典型样本的影响等,并在开发过程中进行了试剂、仪器、算法等方面有针对性的改善,提高了迈克8系列血细胞分析仪对有核红细胞识别的准确度,使其可以在临床应用中发挥更大的价值。
参考文献(滑动):
[1]付善善.血细胞分析仪自动计数外周血有核红细胞的应用研究[J].临床医药文献电子杂志,2018,5(99):147.
[2]张耀东,谭利娜,康文清,刘大鹏,王彩君,李朝辉,周炎娟,熊虹.外周血有核红细胞计数与新生儿缺氧缺血性脑病相关性分析[J].实验与检验医学,2019,37(02):186-189.
[3]刘文平.关于新生儿外周血有核红细胞对白细胞计数的影响研究[J].中国社区医师,2019,35(22):111-113.
[4]张婉琳,崔碧云,邹志杰,黄飞龙.血液病患者外周血有核红细胞对白细胞计数的影响[J].中国实用医药,2019,14(14):84-85.
[5]许诚笛,宋珊珊,高谦,陈燕,陈明坤.Sysmex XN-9000血液分析仪检测有核红细胞的临床应用评价[J].第二军医大学学报,2019,40(07):743-748.
[6]王春霞.探讨血细胞分析仪自动计数外周血有核红细胞的实际应用效果[J].智慧健康,2019,5(31):13-14.19.
[7]王福生,兆钟瑶.酸溶血试验阳性的遗传性幼红细胞多核症[J].国外医学.输血及血液学分册,1982(01):14-18.
[8]Bianchi P., Schwarz K., Högel J., Fermo E., Vercellati C., Grosse R., et al. Analysis of a cohort of 101 CDAII patients: description of 24 new molecular variants and genotype-phenotype correlations. Br. J. Haematol. (2016). 175, 696–704.
[9]胡丰婵.新生儿白细胞计数遇有核红细胞严重干扰纠正1例[J].中国乡村医药,2018,25(09):47+49.
[10] 贾中伟,陆琼,沈继龙.外周血出现有核红细胞患者网织红参数与乳酸脱氢酶分析的意义[J].现代检验医学杂志,2007(01):41-43.

